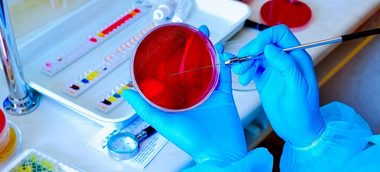

Cercetătorii de la Universitatea din Pittsburgh au dezvoltat un nou model asemănător unui embrion, derivat din celule adulte, care reproduce caracteristici cheie ale dezvoltării umane timpurii, inclusiv generarea de celule sanguine.
Descris recent în revista Nature, noul model heX-Embrioid oferă o perspectivă unică asupra dezvoltării umane timpurii, care a fost învăluită în mister din cauza provocărilor etice şi tehnice legate de studierea acestei perioade a vieţii.
HeX-Embrioizii, care nu folosesc ţesut fetal şi nu se pot dezvolta într-un embrion, ar putea îmbunătăţi cercetarea în domeniul bolilor genetice şi al infertilităţii şi ar putea produce celule pentru a înlocui sau repara ţesuturile pentru aplicaţii în medicina regenerativă.
„Embrionii umani – spre deosebire de cei din alte specii, inclusiv unele dintre cele mai apropiate rude ale noastre, primatele, se încorporează în peretele uterin pentru a continua dezvoltarea. Deoarece embrionul este mai mic decât vârful unui ac de cusut şi este ascuns vederii, aceste stadii timpurii sunt dificil de studiat”, explică autorul principal, dr. Mo Ebrahimkhani, profesor asociat la departamentul de patologie, la Institutul hepatic din Pittsburgh şi la departamentul de bioinginerie de la Pitt.
Echipa speră că modelul asemănător unui embrion va debloca „cutia neagră” a dezvoltării umane, ceea ce ar putea ajuta la rezolvarea misterului de ce aproximativ 60% dintre sarcini eşuează în primele două săptămâni – înainte ca mama să nu aibă nici măcar o menstruaţie – şi va deschide calea pentru noi terapii.
În mod remarcabil, modelele heX-Embryoid au format structuri similare cu primele situsuri de producere a celulelor sanguine care susţin embrionul în curs de dezvoltare, numite insule de sânge.
Cercetătorii au detectat, de asemenea, progenitori de celule roşii din sânge, trombocite şi diferite tipuri de celule albe din sânge.
Potrivit lui Ebrahimkhani, generarea de celule sanguine este un progres cheie al acestui model de embrion.
„Am reuşit să modelăm ceva extrem de asemănător cu primele etape de producere a sângelui la om”, a declarat Ebrahimkhani, care este, de asemenea, membru al Centrului de cercetări ale ficatului, la Pittsburgh, şi al Institutului de medicină regenerativă McGowan din cadrul Pitt şi UPMC (Centrul medical al universităţii Pittsburgh).
Odată cu această reuşită, cercetătorii de la Pitt spun că există posibilităţi extinse de a aplica modelul pentru a înţelege mai bine modul în care se formează sângele şi pentru a dezvolta metode mai bune de creştere a celulelor pentru transfuzii de sânge, terapii celulare noi şi transplanturi de celule stem hematopoietice.
Pentru a dezvolta heX-Embrioizi, cercetătorii au început cu celule stem pluripotente induse (CSPi), care sunt generate din celule adulte care au fost readuse într-o stare în care se pot dezvolta în orice altă celulă.
Apoi au programat aceste CSPi cu un circuit genetic care dirijează dezvoltarea timpurie a ţesuturilor, care este activat doar de o substanţă chimică numită doxiciclină.
Atunci când aceste CSPi modificate sunt amestecate într-un vas de laborator cu CSPi standard şi induse prin adăugarea de doxiciclină, celulele modificate cresc şi declanşează organizarea CSPi standard în structuri tridimensionale care seamănă cu anumite caracteristici ale unui embrion.
În dezvoltarea embrionară normală, celulele se sortează şi se divid în mod repetat pentru a forma în cele din urmă secţiuni distincte: trofoblastul, care va deveni placenta, un strat celular extraembrionar din care ia naştere sacul vitelin, care furnizează nutrienţi şi stratul embrionar care va da naştere embrionului propriu-zis şi sacului amniotic care protejează embrionul în curs de dezvoltare.
La fel ca un embrion, heX-Embrioizii au ţesut embrionar şi o structură de sac vitelin. Ţesutul rămâne ancorat de vasul de laborator pe măsură ce creşte, formând o foaie mare de sac vitelin cu zeci de embrioni aşezaţi unul lângă altul.
„Sacul vitelin nu contribuie în mod direct la producerea celulelor care formează embrionul, dar este un ţesut foarte important, deoarece este responsabil de hrănire şi influenţează locul în care vor fi poziţionate capul şi coada embrionului”, a declarat autorul principal Joshua Hislop, un student absolvent în laboratorul lui Ebrahimkhani de la Pitt.
Potrivit acestuia, alte modele asemănătoare embrionilor au avut o diferenţiere foarte limitată a ţesutului sacului vitelin, astfel încât modelul reuşit acum oferă o oportunitate unică de a urmări în mod robust această structură şi de a studia evenimente precum dezvoltarea sângelui.
HeX-Embrioizii nu conţin stratul de trofoblast care formează placenta, iar sacul vitelin este deschis, nu o cavitate închisă.
Lipsa acestor caracteristici împiedică embrioizii să devină un adevărat embrion sau să aibă potenţialul de a fi implantaţi pentru a se dezvolta complet.
Deoarece heX-Embrioizii sunt derivaţi din celule cutanate adulte reprogramate, aceştia ar putea fi teoretic obţinuţi de la orice individ, permiţând cercetătorilor să studieze diverse medii genetice.
Un avantaj important al sistemului heX-Embrioid faţă de alte modele asemănătoare embrionilor este faptul că se auto-organizează pe măsură ce creşte din vasul bidimensional de laborator, utilizează medii de creştere standard şi este pornit de o singură substanţă chimică, în loc să se bazeze pe un cocktail complicat de factori de creştere care poate fi dificil de reprodus.
Potrivit lui Ebrahimkhani, această abordare unică înseamnă că heX-Embrioizii pot fi uşor depozitaţi, expediaţi şi crescuţi în diferite laboratoare cu un nivel ridicat de eficienţă.
„Pentru ca un model să fie adoptat de comunitatea ştiinţifică şi să îşi facă treaba de a contribui la noi descoperiri, trebuie să fie eficient”, a declarat Ebrahimkhani.
Potrivit cercetătorului american ar fi foarte dificil să se facă progrese în cercetarea avortului spontan dacă modelul în sine eşuează în cea mai mare parte a timpului. Modelul heX-Embrioid depăşeşte această problemă, spune el.